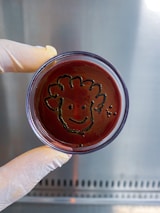

11- 97841-9039 | contato@labbe.vet.br Resultados de Exames Requisição Online
Entre em Contato Conosco
Estamos aqui para ajudar com seus exames laboratoriais veterinários.


Sobre o Labbe Veterinário
No Labbe, oferecemos exames laboratoriais precisos para auxiliar veterinários no diagnóstico e acompanhamento da saúde animal. Agende sua coleta conosco.

Nossa Especialidade
Localizado em Santo André, somos especializados em análises de sangue, urina e fezes, garantindo suporte essencial para a saúde dos animais.
LABBE Laborátorio Veterrinário
Qualidade e excelência para oferecer o melhor em exames laboratoriais.
Contato
Localização
contato@labbe.vet.br
+55 11 97841-9039
© 2025. All rights reserved.
Rua Bororós, 281 - Santo André - SP
Segunda à Sexta
Das 9h00 às 18h00
Sábado
Das 09h00 às 15h00
Domingo e Feriados
Sob consulta
